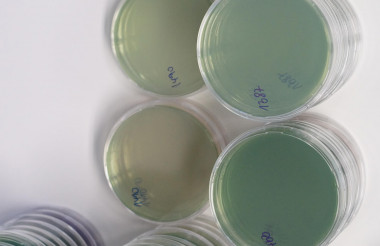
Laboruntersuchung Legionellenprüfung

Legionellenprüfung
Trinkwasseruntersuchung alle 3 Jahre wiederholen!
Die Betreiber bzw. Eigentümer einer Trinkwassererwärmungsanlage sind verpflichtet, ihre Warmwasseranlage alle 3 Jahre auf Legionella spec. untersuchen zu lassen. Davon betroffen sind praktisch alle zentralen Warmwasserversorgungsanlagen in Mehrfamilienhäusern, in denen Wohnungen vermietet, entgeltlich zur Nutzung überlassen oder für sonstige gewerbliche Zwecke genutzt werden.
Eine Legionellenbeprobung im Objekt muss erfolgen wenn...
- das Objekt drei oder mehr Wohneinheiten hat
- mindestens eine Wohneinheit vermietet ist
- das Objekt eine zentrale Anlage zur Trinkwassererwärmung hat
- es im Objekt Duschmöglichkeiten gibt
- das Volumen des Warmwasserspeichers mehr als 400l hat
- oder der Inhalt in mindestens einer Rohrleitung zwischen Warmwasserspeicher und der am weitesten entfernten Entnahmestelle (z.B. Wasserhahn) mehr als drei Liter beträgt.

Probenahme
Als Ihr Dienstleister vor Ort unterstützen wir Sie bei der Umsetzung Ihrer turnusmäßigen Legionellenprüfung.
Probenahme und Untersuchung
Nach Umsetzung der organisatorischen und technischen Voraussetzungen zur Probenahme kann die orientierende Prüfung erfolgen.
Untersuchungsverfahren und Untersuchungsstellen
Nur staatlich zugelassene Labore dürfen die Wasserprobe analysieren. Diese müssen in der jeweiligen Landesliste der Gesundheitsämter gelistet sein. Sowohl der Versand der entnommenen Wasserprobe als auch die Weiterleitung der Untersuchungsergebnisse müssen unter Einhaltung vorgeschriebener Fristen erfolgen.
Unser Kooperationspartner für die Trinkwasseranalysen ist ausschließlich ein akkreditiertes Labor, das bei der Deutschen Akkreditierungsstelle (DAkks) gelistete ist. Probenahme und Analyse sind also in der Hand des Labors, die Koordination erfolgt durch asko. Die dabei unterstützenden Probenehmer sind in das Qualitätsmanagement des Labors eingebunden.
Mehr zum Thema Trinkwasserverordnung finden Sie in unserer aktuelle Meldungen und Urteile

- Bestandsaufnahme und Dokumentation der Hausinstallation Wasser
- Festlegung der Probenahmestellen durch hygienisch-technisch kompetentes Personal
- Anzeige Gesundheitsamt nach § 11 TrinkwasserVO
- Turnusmäßigen Probenahme im Auftrag der akkreditierten Untersuchungsstelle nach § 41 und 42 TrinkwasserVO
- Analytik und Auswertung in der vom Anlagenbetreiber beauftragenden und akkreditierten Untersuchungsstelle
- Benachrichtigung zuständiges Gesundheitsamt durch Untersuchungsstelle
- Erstellung der Dokumentationen für Anlagenbetreiber (UsI), Gesundheitsamt, Verrbaucher
- Benachrichtigung Anlagenbetreiber (UsI) über Ergebnis der Wasseruntersuchung mit Unterlagen für Verrbaucher
- Archivierung der Untersuchungsergebnisse (10 Jahre) gegebenenfalls Einleitung weiterer notwendiger Maßnahmen in Abstimmung mit Auftraggeber, Gesundheitsamt und Fachfirmen